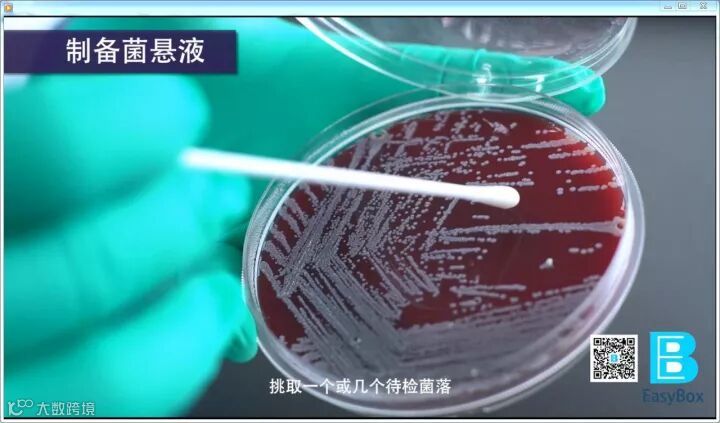

API系统将含有供不同生化试验用的脱水底物整合到小管组合的试剂条中,试验时将培养物制成菌悬液,分注于各个小管内,并在指定的小管上加上矿物油,然后在适宜的温度培养一定时间,取出观察各孔的颜色变化,最后将生化反应结果转为数值编码,从而获得鉴定结果报告。
套盒内容
API套盒内容包括:主试条、主试剂、附加试剂、产品说明书及试验报告单、配套培养盒、一次性棉签与滴管(10测试套盒)。
二维码使用
通过扫描套盒侧身二维码,在线获取COA证书、注册证、产品说明书、操作视频等电子版资料。
开始试验
打开配套培养盒的盖子,在培养盒底座中加入约5ml蒸馏水。
挑取一个或几个待检菌落,洗入盐水培养基或无菌悬浮液中,制成一定麦氏标准浊度的菌悬液。

用同一根滴管吸取菌悬液接种至试条的反应孔。

接种后盖好盖子,将试条置于适宜温度需氧环境中培养。
试条培养一定时间后,按照说明书在相应试孔中加入附加试剂。待发生颜色变化后,将试条与标准色卡进行比对,并填写报告单。
查询鉴定结果

有奖问答
肠杆菌科细菌鉴定要选择哪种试剂条呢?
A、20E
B、20NE
C、20A
D、50CH
关注【广州一盒】官方微信公众号并回复答案
前三名答中者可获得50元话费充值福利
活动真实有效!快来参与吧!
↓↓↓
文、图 | 源自广州一盒

